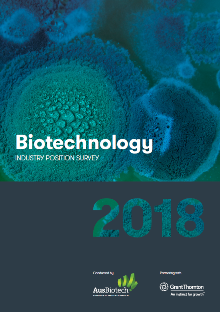
Grant Thornton Australia

This is the eighth Biotechnology Industry Position Survey conducted by AusBiotech and supported by Grant Thornton. The 2018 Survey reveals the strongest ever business sentiment across the sector.
The number who described the environment as conducive to growing a biotechnology company has almost returned to 2016 levels after a fall last year in response to uncertainty over the future of the R&D Tax Incentive.
The return of more positive sentiment towards the environment also comes as the recent announcement in the 2018-19 Budget of changes to the R&D Tax Incentive exempted investment in clinical trials from the new $4 million annual cap on the refundable component.
Key findings in the report include:
- Biotech booming
- Value of clinical trials recognised and supported
- Snapshot shows a larger sector than expected
- Skills and talent attraction looms as significant issue
77% of respondents described the past twelve months as an ‘excellent’ or ‘good’ year, up from 72 percent in the 2017 survey.
Almost 90 percent of respondents said they expect to grow in 2018.
“Businesses in Australia’s life sciences sector are optimistic about their future growth, and rightly so. The Government recognition of clinical trials when altering the R&D tax exemption is a testament to the advocacy of AusBiotech and how the industry is being increasingly recognised for its contribution to the economy.”
Michael Cunningham - National Head of Life Sciences
Also appears under...